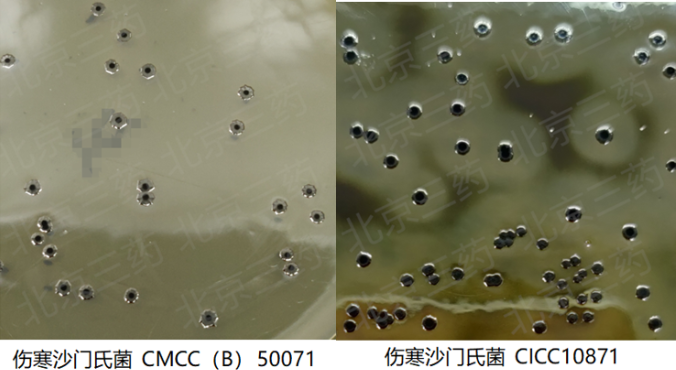

沙門(mén)氏菌是世界上食源性腹瀉最常見(jiàn)的病原菌之一。全球每年估計發(fā)生13億因沙門(mén)氏菌導致的急性腸胃炎病例,其中300萬(wàn)患者死亡。我國沙門(mén)氏菌食物中毒多年來(lái)居細菌性食物中毒的首位,英國吉百利巧克力事件、美國的花生醬事件、匈牙利400多人甜食中毒事件等等,均是沙門(mén)氏菌污染所致,引起了各國重視,并將其列為出入境檢驗檢疫的法定檢查項目。

該培養基中蛋白胨、牛肉膏為細菌生長(cháng)提供所需的氮源、營(yíng)養物質(zhì)等;葡萄糖作為碳源;磷酸氫二鈉為培養基緩沖劑;煌綠和亞硫酸鈉可抑制大腸桿菌、變形桿菌和革蘭氏陽(yáng)性菌的生長(cháng),但對沙門(mén)氏菌的生長(cháng)無(wú)影響;傷寒沙門(mén)氏菌和其他沙門(mén)氏菌可利用葡萄糖,將亞硫酸鹽還原成硫化物并與硫酸亞鐵反應使得菌落呈黑色,同時(shí)將鉍離子還原成金屬鉍使菌落呈現金屬光澤;瓊脂為凝固劑。
培養基配制注意事項:本培養基不需要高壓滅菌,在制備過(guò)程中不宜過(guò)分加熱,避免降低其選擇性;宜于當天配置第二天使用,配置后平板為淡綠色不透明的凝膠狀固體。
BS瓊脂培養基質(zhì)量要求
在GB4789.28-2013 培養基和試劑的質(zhì)量要求中關(guān)于亞硫酸鉍瓊脂(BS)的質(zhì)量控制標準為:

自本實(shí)驗室中選取11株沙門(mén)氏菌在TSB肉湯中活化后接種于BS瓊脂平板,36℃±1℃培養40h-48h觀(guān)察不同沙門(mén)氏菌的菌落形態(tài),是否均產(chǎn)生金屬光澤。
具體沙門(mén)氏菌菌株如下:

置于36℃±1℃,培養40h時(shí)觀(guān)察產(chǎn)生金屬光澤的情況。
經(jīng)觀(guān)察,以上11株沙門(mén)氏菌培養后為黑色或灰綠色菌落,均產(chǎn)生明顯的金屬光澤,不同菌株的菌落形態(tài)略有差異,回收率均在87%以上。
具體沙門(mén)氏菌菌落形態(tài)參考下圖:

本培養基要求抑制大腸埃希氏菌,避免對沙門(mén)氏菌的分離產(chǎn)生干擾;同時(shí)抑制革蘭氏陽(yáng)性菌-糞腸球菌,故自實(shí)驗室中選取5株大腸埃希氏菌和7株糞腸球菌進(jìn)行驗證。
.png)
36℃培養40h后計數生長(cháng)指數G值,結果如下:

經(jīng)試驗驗證,5株大腸埃希氏菌和7株糞腸球菌均被抑制。
亞硫酸鉍瓊脂(BS)(產(chǎn)品號:12C04)平板上生長(cháng)的多株沙門(mén)氏菌的菌落形態(tài)典型,可產(chǎn)生明顯的金屬光澤,易與其他雜菌區分。在進(jìn)行沙門(mén)氏菌檢測的過(guò)程中,同時(shí)需要與其他選擇性分離平板(如XLD、HE或沙門(mén)氏菌顯色培養基)上分離的典型和可疑菌落純化后進(jìn)行后續的生化與血清學(xué)鑒定,綜合分析判斷是否為沙門(mén)氏菌。
原文鏈接:研究進(jìn)展 || 多株沙門(mén)氏菌在亞硫酸鉍瓊脂(BS)上的生長(cháng)情況。